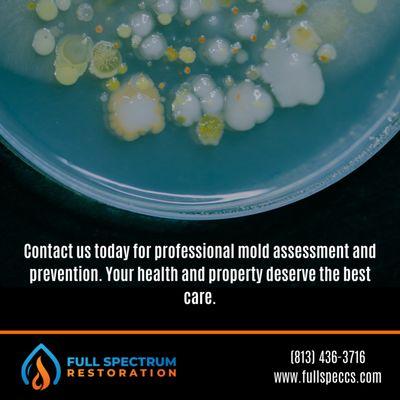

LiftStyle Garage Door
Open
3690 W Gandy Blvd
Tampa, FL 33611
Garage Door Repair USA has been a trusted leader in reliable and high-quality garage door services for over 20 years. Their skilled professionals specialize in installation, urgent repairs, and regular maintenance, ensuring outstanding results with a commitment to customer satisfaction.
The company employs licensed and insured technicians who utilize durable materials for long-lasting workmanship. With a focus on fast, efficient service, they offer same-day assistance, 24/7 emergency repairs, and affordable pricing, making them a go-to choice for garage door needs.
Generated from the website
Also at this address
See a problem?